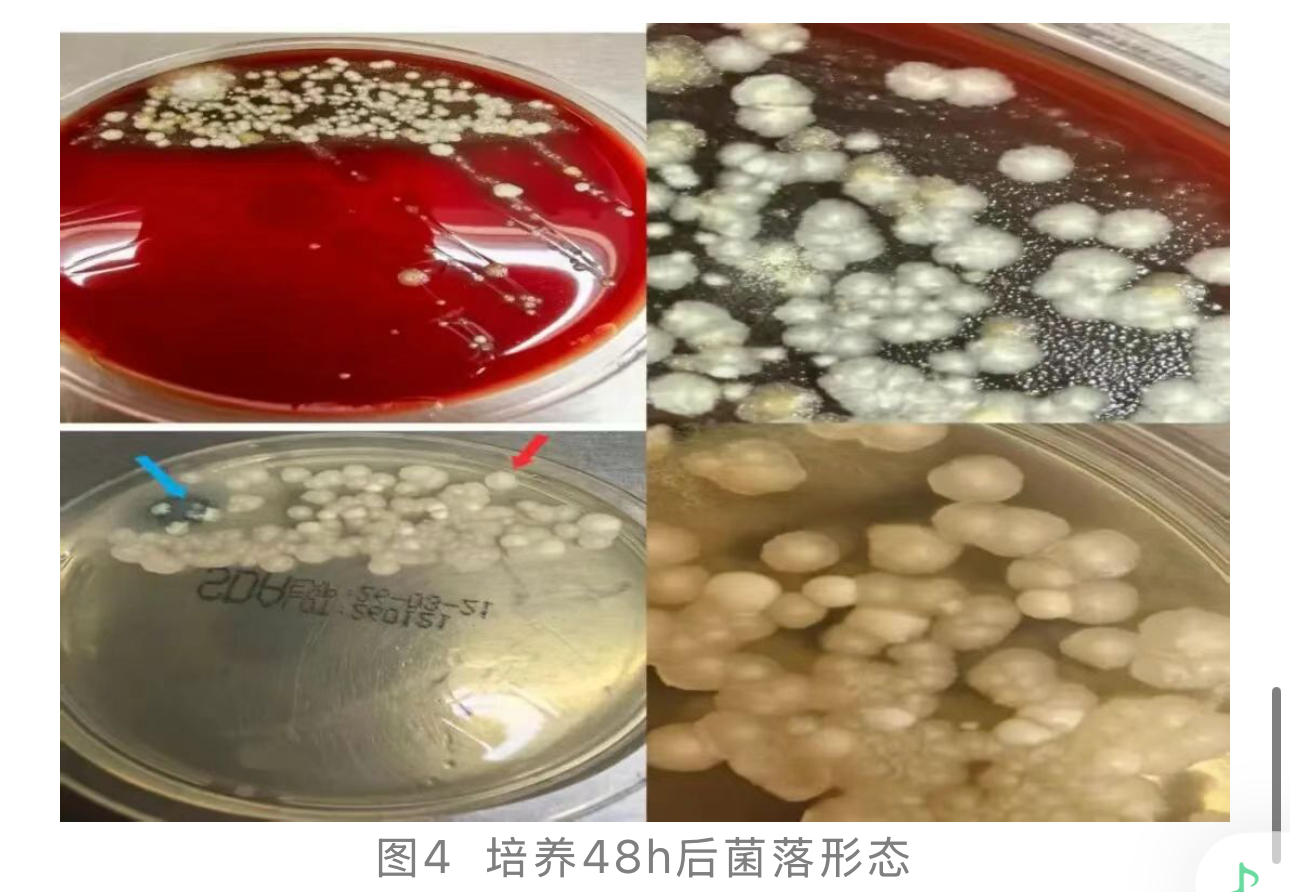
1774247224943149.jpg 1774247224943149.jpg

肺内“潜伏者”:一例被tNGS遗漏的头状大孢酵母
作者:陈样芬,江门市中心医院检验科
头状大孢酵母(Magnusiomyces capitatus)隶属于真菌界子囊菌门、酵母菌纲、酵母菌目、双足囊菌科、大孢酵母菌属。最初依据其形态学特征被归于地霉属(Geotrichum)或芽生裂殖菌属(Blastoschizomyces)[1,2];随后基于分子生物学证据(如ITS序列分析)被重新归类至腐生酵母属,更名为头状腐生酵母(Saprochaete capitata);
到了2004年,根据核糖体DNA(rDNA)基因序列的系统发育分析又将其转移到大孢酵母属(Magnusiomyces capitatus/Saprochaete capitata)[3],2011年根据“一种真菌 = 一个名字”的命名原则,统一命名为头状大孢酵母( Magnusiomyces capitatus)[4]。
头状大孢酵母主要存在于自然环境中,如土壤、沙、木浆。也可从禽类的粪便、胃肠道、呼吸道分离出,也可定植人体皮肤、消化道、呼吸道。是一种罕见的条件致病真菌,主要感染免疫功能严重受损的宿主,尤其是恶性血液病
患者(如急性白血病
)和造血干细胞移植
受者。
本文报道1例活动性肺结核
患者合并头状大孢酵母等多重感染,诊疗中头状大孢酵母经肺泡灌洗液涂片
+培养确诊,却因tNGS技术局限漏检。临床医生过度依赖tNGS报告,未能依据微生物学“金标准”及时治疗。
本案例旨在深入探讨该菌的鉴定难点、不同检测技术的局限与互补价值,以及如何综合解读矛盾结果以避免临床决策偏差,提升对这类复杂感染的诊治水平。
案例经过
男性,76岁,主诉“咳嗽
咳痰10余年,再发伴头晕乏力1年”,于2026年1月25日入院。
现病史:
患者于10余年前出现咳嗽咳痰,咳嗽、咳痰与天气变化、体位
改变无明显关系。1年前症状再次发作,伴头晕双下肢乏力不适,对症治疗后仍反复发作。10天前患者头晕乏力加重,我院门诊就诊,完善头颅CT及颅脑MR未见明显异常,现患者咳嗽、咳痰加重,今为求进一步治疗,于我院门诊就诊,门诊拟“肺部感染”收入我院呼吸与危重症医学科一区住院治疗。
既往史:既往“肺结核”病史,于2024年、2025年在我院规范抗结核治疗,自诉已治愈。有“腰椎间盘突出
症”病史,去年于外院行“经皮椎体成形术”。
个人史:长期吸烟史,现5-6支/天。否认否认工业毒物、粉尘、放射性物质接触史。否认冶游史。
入院检查:
(1)查体: 体温 36.3℃,脉搏
75次/分,呼吸 19次/分,血压 127/79mmHg,胸廓无畸形,双侧语音震颤
对称,双肺叩清,呼吸音清,未闻及干湿啰音,未闻及胸膜摩擦音。心前区无异常隆起,无震颤,心界叩不大,HR75次/分,律齐,未闻及病理性杂音。余无异常体征。
(2)实验室检查:白细胞7.65x109/L ↑,中性粒细胞% 76.4%/L ↑,血红蛋白
112g/L ↓,白蛋白
37.2g/L ↓,超敏C反应蛋白 27.56mg/L ↑,白介素-6 8.60pg/mL ↑;尿隐血:1+;呼吸功能检查:FeNO50 24ppb, FeNO200 11ppb, CaNO 5.0ppb。
(3)影像学检查:
胸部CT:右肺,左肺上叶见多发结节状,片状,索条状密度增高影,边界清晰,内见空气支气管征,部分病变内见钙化灶,右肺上叶厚壁空洞形成并与支气管相通。双肺多发斑片状模糊影,右肺为著。(图1)

病原学检查:
(1)2026年1月26日患者行支气管镜肺泡灌洗术,并送培养,烟曲霉、黄曲霉、黑曲霉核酸检测和病原微生物靶向高通量测序(tNGS)。
肺泡灌洗液直接涂片:多条深色,细长且有明显分隔的真菌菌丝,有些菌丝末端有形似“吸盘”的结构。(图2)

(2)2026年1月27日病原微生物靶向高通量测序结果示致病病原体:结核分枝杆菌
;可疑致病病原体:烟曲霉、白色念珠菌、ERV、CMV。(图3)

(3)2026年1月28日肺泡灌洗液培养结果如下:
哥伦比亚血平板35℃培养48h后可见白色扁平,干燥,略带锯齿状,表面呈磨砂玻璃样的菌落;沙保罗平板35℃培养48h可见白色至淡黄色,锯齿状无光泽粗糙菌落,菌落形态与酵母菌相似。(图4)
沙保罗平板的红色箭头菌落进行涂片并革兰氏染色,高倍镜下可见有分隔的真菌丝与假菌丝,孢子主要为圆柱形或棒状,顶端圆形、基部平截。(图5)

将沙保罗琼脂上的培养48h的菌落用质谱仪进行鉴定,红色箭头(图4)菌落鉴定为Saprochaete capitata:头状腐生酵母(现已统一命名:头状大孢酵母Magnusiomyces capitatus),见(图6);蓝色箭头(图4)菌落鉴定为Aspergillus fumigatus :烟曲霉。
(4)2026年1月28日肺泡灌洗液烟曲霉、黄曲霉、黑曲霉核酸(PCR)检测:检出。
临床治疗:
患者入院初始给予头孢拉定
抗感染、化痰止咳、平喘等对症支持治疗;临床医生初步评估时,主要依据tNGS报告,诊断为“肺结核合并肺曲霉病可能”,鉴于肺结核为明确活动性感染,建议患者转至当地结核防治所进行规范抗结核治疗,患者同意并出院治疗肺结核。
案例分析
头状大孢酵母(Magnusiomyces capitatus)隶属于真菌界子囊菌门、酵母菌纲、酵母菌目、双足囊菌科、大孢酵母菌属。
菌落形态:生长速度中等,血平板、PDA培养基和SDA培养基上菌均可生长。菌落颜色为白色,延长培养后颜色略加深为淡米黄色,边缘不规则。在科玛嘉念珠菌显色平板上显淡粉色或浅玫瑰红色菌落[5,6]。
镜下形态:可见真菌丝和假菌丝、芽生孢子、似关节孢子样的环痕孢子和少量关节孢子。环痕孢子透明,光滑,单细胞,圆柱形到棒形,孢子顶端具有扁平的基底。菌丝呈锐角分枝,顶生或间生的产孢细胞可形成长条形的环痕状凸起,由此处产生分生孢子[5,6]。
鉴定方法:鉴定头状大孢酵母时,强烈推荐进行培养以获得纯菌落,传统形态学镜检寻找环痕孢子是关键初筛特征;基质辅助激光解吸电离飞行时间质谱(MALDI-TOF MS)是临床快速鉴定的常用手段,表型及质谱鉴定为中度推荐(其准确性与所用系统及数据库相关)。
全自动生化鉴定系统(如 VITEK 2,在数据库支持完善时准确率较高)可作为辅助手段[7];菌种最终鉴定强烈推荐采用分子生物学方法(如 ITS 区测序)[8]。最佳实践是将自动化鉴定结果与镜下形态相互印证。
头状大孢酵母(Magnusiomyces capitatus)为条件致病性真菌,好发于伴有重度、持久中性粒细胞缺乏的恶性血液病患者(尤其是急性白血病),接受造血干细胞或实体器官移植等强效免疫抑制治疗的宿主,也可累及免疫功能正常人群[9-11]。其中肺部感染多表现为气促、咳嗽等症状;影像学常见表现为双肺弥漫性浸润影、磨玻璃影、胸腔积液
及肺实质结节等[9]。
根据2021年ECMM/ISHAM/ASM联合指南[8],头状大孢酵母感染需明确感染证据后精准干预,初始治疗可选用含两性霉素 B 制剂联合或不联合氟胞嘧啶
,亦可联合伏立康唑
治疗;泊沙康唑
可作为替代方案。需注意,该菌对棘白菌素类和氟康唑
表现出高MIC值,故不推荐使用。最终方案应基于药敏试验
和患者具体情况个体化制定。
本案例中的肺结核患者虽非经典高危人群,但其临床背景仍构成了明确的感染风险框架:首先,活动性肺结核所致的肺组织结构性破坏(如空洞形成)直接破坏了呼吸道黏膜屏障,为真菌定植提供了病理解剖基础。
其次,肺结核病作为消耗性疾病,常伴随营养不良
及潜在的细胞免疫功能抑制,构成了机会性感染的条件。更为关键的是,在抗结核或治疗继发细菌感染过程中,广谱抗生素的暴露可导致呼吸道菌群失调,形成对头状大孢酵母有利的“选择压力”。
本案例清晰地展示了在无经典高危血液病背景的情况下,由“局部解剖屏障破坏”、“基础疾病相关免疫耗竭”与“医源性药物选,三重风险叠加所构成的感染通路。
病原微生物靶向高通量测序(tNGS)的检测能力受限于其预设的病原体基因数据库(Panel)。本实验室所用Panel未涵盖头状大孢酵母,直接导致该病原体在本例tNGS结果中未被检出。
该案例中,活动性肺结核患者的肺泡灌洗液(BALF)呈现出多病原体共存的复杂局面,tNGS未检出头状大孢酵母,而传统镜检与培养明确检出头状大孢酵母。临床医生决策仅依据tNGS结果(其Panel未涵盖该酵母)聚焦于明确的结核分枝杆菌和烟曲霉,让患者回结核防所治疗,完全忽视了培养这一诊断“金标准”的阳性发现,构成严重的诊疗偏差。
从病原学风险层级分析,头状大孢酵母在BALF中镜检与培养双阳性,高度提示侵袭性感染,尤其该患者存在肺结核空洞所致的局部屏障破坏与潜在免疫消耗,感染风险极高。未对已证实的头状大孢酵母进行针对性抗真菌治疗,将使患者暴露于感染快速进展乃至播散的致命风险之中。
核心启示:对现代诊断技术的理性审视
1. 技术认知是正确解读的前提:临床医生必须了解所申请检测(如tNGS)的原理、数据库覆盖范围及其技术局限性。
2. 坚持病原学诊断的“三角互证”原则:任何单项检测均有局限。临床决策应基于对直接镜检、培养与分子检测(核酸) 结果进行批判性综合评估。当结果矛盾时,应赋予传统镜检与培养的阳性结果更高权重。
3. 回归临床思维本质:诊断应以患者的具体病理生理背景(结构性肺病、免疫状态、暴露史)为基石,而非单纯依赖或迷信某一项先进的检测报告。
案例总结
本病例为肺结核病史患者合并多重病原体感染,核心争议点在于头状大孢酵母的检出差异与治疗决策。肺泡灌洗液涂片+培养对头状大孢酵母的检出具有不可替代的价值,而tNGS可能因技术局限性出现漏检,临床需结合多种检测手段综合判断。
在多重感染场景下,优先控制结核分枝杆菌这类核心致病菌是合理选择,但需警惕头状大孢酵母等条件致病菌的潜在危害,建议通过随访明确是否需要启动抗真菌治疗。
临床诊疗中需重视实验室检测与临床实际的结合,避免单一依赖某类检测技术,同时在多重感染的治疗决策中兼顾有效性与安全性。
本文审核专家:
李姝,河南省沁阳市人民医院,副主任检验技师
参考文献略
来源:数智检验医学